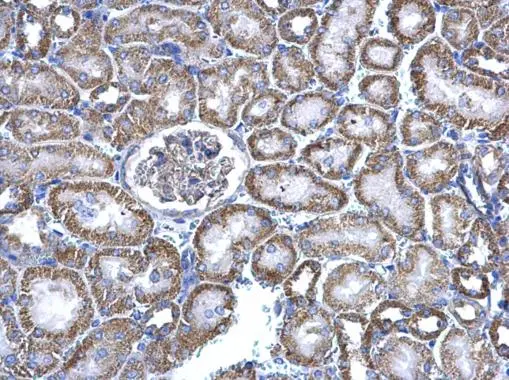
NNT antibody detects NNT protein at cytosol on mouse kidney by immunohistochemical analysis. Sample: Paraffin-embedded mouse kidney. NNT antibody (GTX103015) dilution: 1:500. 
 Antigen Retrieval: Trilogy? (EDTA based, pH 8.0) buffer, 15min

NNT antibody detects NNT protein at mitochondria by immunofluorescent analysis. Sample: HeLa cells were fixed in ice-cold MeOH for 5 min. Green: NNT stained by NNT antibody (GTX103015) diluted at 1:500.
NNT antibody
GTX103015
ApplicationsImmunoFluorescence, Western Blot, ImmunoCytoChemistry, ImmunoHistoChemistry, ImmunoHistoChemistry Paraffin
Product group Antibodies
ReactivityHuman, Mouse, Rat
TargetNNT
Overview
- SupplierGeneTex
- Product NameNNT antibody
- Delivery Days Customer9
- Application Supplier NoteWB: 1:500-1:3000. ICC/IF: 1:100-1:1000. IHC-P: 1:100-1:1000. *Optimal dilutions/concentrations should be determined by the researcher.Not tested in other applications.
- ApplicationsImmunoFluorescence, Western Blot, ImmunoCytoChemistry, ImmunoHistoChemistry, ImmunoHistoChemistry Paraffin
- CertificationResearch Use Only
- ClonalityPolyclonal
- Concentration0.23 mg/ml
- ConjugateUnconjugated
- Gene ID23530
- Target nameNNT
- Target descriptionnicotinamide nucleotide transhydrogenase
- Target synonymsGCCD4, NAD(P) transhydrogenase, mitochondrial, pyridine nucleotide transhydrogenase
- HostRabbit
- IsotypeIgG
- Protein IDQ13423
- Protein NameNAD(P) transhydrogenase, mitochondrial
- Scientific DescriptionThis gene encodes an integral protein of the inner mitochondrial membrane. The enzyme couples hydride transfer between NAD(H) and NADP(+) to proton translocation across the inner mitochondrial membrane. Under most physiological conditions, the enzyme uses energy from the mitochondrial proton gradient to produce high concentrations of NADPH. The resulting NADPH is used for biosynthesis and in free radical detoxification. Two alternatively spliced variants, encoding the same protein, have been found for this gene. [provided by RefSeq]
- ReactivityHuman, Mouse, Rat
- Storage Instruction-20°C or -80°C,2°C to 8°C
- UNSPSC41116161